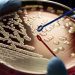

La exhibición se ubica en el Campus Curauma de nuestra institución, donde la mayoría de los animales de la colección recibieron el cuidado experto del reconocido taxidermista José Carpeneto.
Más de 130 aves, mamíferos, peces y reptiles embalsamados; esqueletos bípedos, tenias, lombrices y corales marinos forman parte de la gran colección de especies del Instituto de Biología de la Pontificia Universidad Católica de Valparaíso (PUCV), muestra que busca difundir el conocimiento sobre el reino animal y que está especialmente dirigida a los estudiantes escolares.
La muestra -ubicada en el campus Curauma de la casa de estudios– se encuentra disponible para visitas guiadas destinadas a colegios. El objetivo es hacer las clases más interactivas y entregar conocimientos ligados a la biología de manera lúdica.
“El valor que tiene esta colección está muy ligado a la educación de estudiantes de enseñanza básica, media y universitarios que cursan las carreras de Pedagogía en Biología y Ciencias Naturales y Licenciatura en Biología en sus ramos de zoología”, dijo Sebastián González, académico e investigador PUCV, quien recibe a los asistentes.
Al ingresar al espacio, lo primero que llama la atención de los niños, adolescentes y jóvenes, son los animales de mayor tamaño, como el ave de altamar albatros real que pesa 8,5 kilos; el pez cachalote que es similar a un tiburón y el pez luna o mola mola que se encuentra en una de las paredes del recinto, justo arriba de animales como el huemul, el zorro culpeo y el gato colo colo.
“Hay adaptaciones que tiene cada mamífero para vivir en el ambiente que nosotros enseñamos en las visitas. Explicamos el porqué un flamenco come de cabeza, por ejemplo. También profundizamos en el ciclo de contagio de la lombriz solitaria. Los niños quedan impresionados porque no dimensionan su tamaño”, dijo el académico.
Abejas, arañas, búhos, pingüinos, libélulas, mariposas, castores, guacamayos y cráneos de pumas, también se encuentran exhibidos en el museo donde también hay dos mamíferos nacionales que están en riesgo de extinción.
“En Chile hay bastantes especies con categoría de conservación preocupante. El gato colo colo y el gato andino están calificados como tal, por eso es de suma importancia enseñar y crear conciencia de que esos animales están en peligro. La idea es conocer para proteger”, afirmó González.
La mayoría de los animales de la colección zoológica de la PUCV fueron tratados por el aclamado taxidermista José Carpeneto, encargado de realizar la técnica en algunos museos de historia natural del país. La última especie en completar la sala museo fue un ave en la década de los 70.
Si desea conocer el recinto, puede reservar la visita en el correo paulo.salinas@pucv.cl